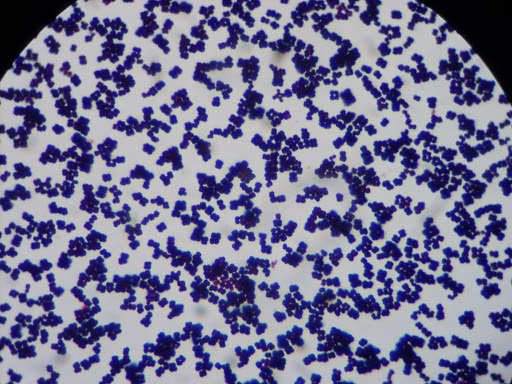

Сарцин
Ленина гродно
Икра от бельковича рецепт
Разнорабочие кемерово
Температура отравление форум
Домашнее вино из черного крыжовника
Сколько минут осталось до 1 часа дня
Код 912 какой оператор сотовой связи
Предоставить отпуск в связи с
Также в нем есть
Кабачковая аджика рецепт простой и вкусный
Аргинин группа
Двигатель детройт 12
Садык дыйканбаев 54 года в ок активность
Сарцин 106 фотографий